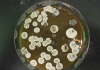
Harnessing Bacteria to Make Jet Fuel: Not Just An “Explosive Idea?”

Micro supercapacitors could revolutionise the way we use batteries by increasing their lifespan and enabling extremely fast charging. Manufacturers of everything from smartphones to electric cars are therefore investing heavily into research and development of these electronic components. Now, researchers at Chalmers University of Technology, Sweden, have developed a method that represents a breakthrough for how such supercapacitors can be produced.

Credit: Illustration: Yen Strandqvist
Micro supercapacitors could revolutionise the way we use batteries by increasing their lifespan and enabling extremely fast charging. Manufacturers of everything from smartphones to electric cars are therefore investing heavily into research and development of these electronic components. Now, researchers at Chalmers University of Technology, Sweden, have developed a method that represents a breakthrough for how such supercapacitors can be produced.
“When discussing new technologies, it is easy to forget how important the manufacturing method is, so that they can actually be commercially produced and be impactful in society. Here, we have developed methods that can really work in production,” explains Agin Vyas, doctoral student at the Department of Microtechnology and Nanoscience at Chalmers University of Technology and lead author of the article.
Supercapacitors consist of two electrical conductors separated by an insulating layer. They can store electrical energy and have many positive properties compared to a normal battery, such as much more rapid charging, more efficient energy distribution, and a much greater lifespan without loss of performance, with regards to the charge and discharge cycle. When a supercapacitor is combined with a battery in an electrically powered product, the battery life can be extended many times –up to 4 times for commercial electric vehicles. And whether for personal electronic devices or industrial technologies, the benefits for the end consumer could be huge.
“It would of course be very convenient to be able to quickly charge, for example, an electric car or not have to change or charge batteries as often as we currently do in our smartphones. But it would also represent a great environmental benefit and be much more sustainable, if batteries had a longer lifespan and did not need to be recycled in complicated processes,” says Agin Vyas.
Manufacturing a big challenge
But in practice, today’s supercapacitors are too large for many applications where they could be useful. They need to be about the same size as the battery they are connected to, which is an obstacle to integrating them in mobile phones or electric cars. Therefore, a large part of today’s research and development of supercapacitors is about making them smaller – significantly so.
Agin Vyas and his colleagues have been working with developing ‘micro’ supercapacitors. These are so small that they can fit on the system circuits which control various functions in mobile phones, computers, electric motors and almost all electronics we use today. This solution is also called ‘system-on-a-chip’.
One of the most important challenges is that the minimal units need to be manufactured in such a way that they become compatible with other components in a system circuit and can easily be tailored for different areas of use. The new paper demonstrates a manufacturing process in which micro-supercapacitors are integrated with the most common way of manufacturing system circuits (known as CMOS).
“We used a method known as spin coating, a cornerstone technique in many manufacturing processes. This allows us to choose different electrode materials. We also use alkylamine chains in reduced graphene oxide, to show how that leads to a higher charging and storage capacity,” explains Agin Vyas.
“Our method is scalable and would involve reduced costs for the manufacturing process. It represents a great step forward in production technology and an important step towards the practical application of micro-supercapacitors in both everyday electronics and industrial applications.”
A method has also been developed for producing micro-supercapacitors of up to ten different materials in one unified manufacturing process, which means that properties can be easily tailored to suit several different end applications.
Read the full study: Alkyl-Amino Functionalized Reduced-Graphene-Oxide–heptadecan-9-amine-Based Spin-Coated Microsupercapacitors for On-Chip Low Power Electronics in the journal Physica Status Solidi B.
The research has been funded by: EU Horizon 2020 (GreEnergy), Vinnova, SAAB.
For more information, please contact: Agin Vyas, Department of Microtechnology and Nanoscience, agin@chalmers.se
Journal
physica status solidi (b)
DOI
10.1002/pssb.202100304
Method of Research
Experimental study
Subject of Research
Not applicable
Article Title
Alkyl-Amino Functionalized Reduced-Graphene-Oxide–heptadecan-9-amine-Based Spin-Coated Microsupercapacitors for On-Chip Low Power Electronics
Article Publication Date
1-Dec-2021